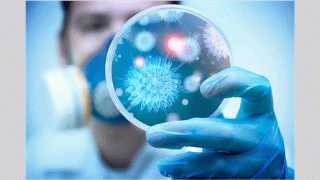

الشركة العامة للبترول تنجح في إضافة نحو 1500 برميل يوميًا من منطقة...وزيرا ”الاستثمار والتجارة الخارجية” و”الصناعة” يشهدان اتفاقية تعاون بين مركز تحديث الصناعة...وزير الشباب والرياضة يبحث مع رئيس شركة ”I events” ترتيبات عدد من...وزيرة التنمية المحلية والبيئة ومحافظ كفرالشيخ ورئيسة المجلس القومي للمرأة يطمئنون على...وزير الشباب والرياضة يلتقي مجلس إدارة نادي هليوبوليس لمتابعة خطط التطوير والأنشطة...